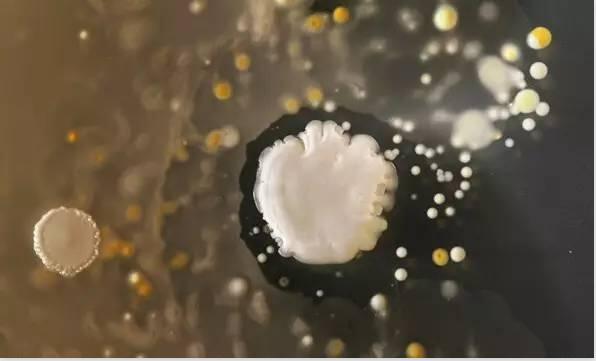
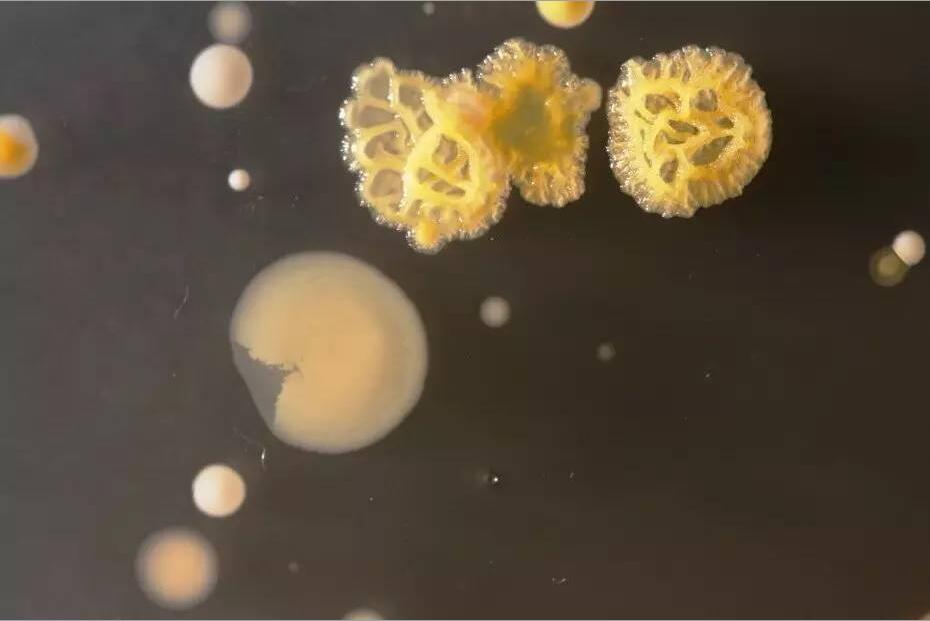
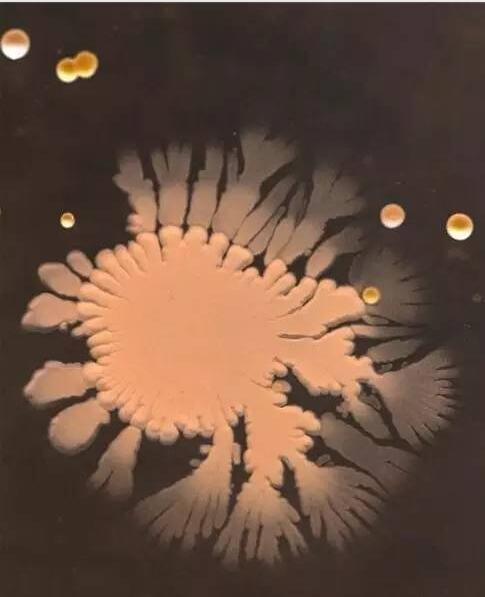

Micro camera captures bacteria
Author : rzadmin
Date : 04/13/2016
Views : 3473
Return
According to research, mobile phones harbor 120000 bacteria per square centimeter. Based on this calculation, the entire phone has at least millions of bacteria, which is enough to make the bacterial community on toilet seats blush. A simple textual description may not shock you, so let's explore what these bacteria look like under a microscope with you through the Micro series cameras.
The latest Micro series microscope camera developed by Smart Image (click to view parameter information) is applied in high-end microscopes and can capture them clearly.

You can clearly see a large number of bacteria on your phone, although most of them are harmless, there are also bacteria that carry diseases, such as Staphylococcus aureus.
We can see it more clearly under the MicroUH1200 model, which has a pixel size of 4000x3000; Target surface 1/1.7

Have you been shocked by these clear photos? It was the Micro series microscope cameras that allowed us to discover them.
The Micro series microscope camera is designed for high-end microscopes and has a tendency towards perfect performance in the field of microscopes. It has received unanimous praise from industry professionals in terms of image clarity, color reproduction, and product stability.